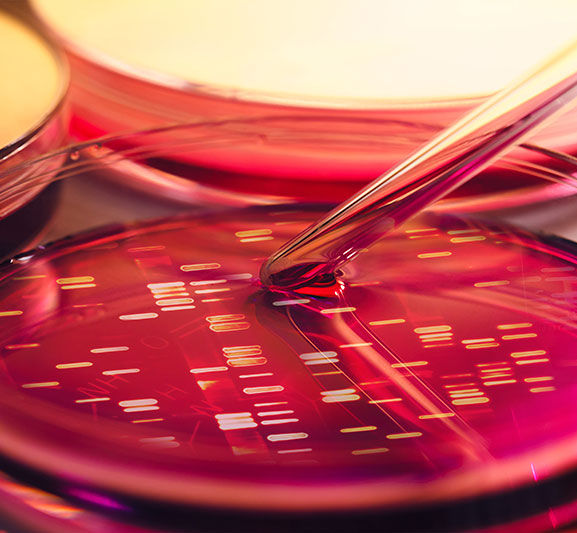

Unlocking the Mysteries of global Clinical Trials
Clinical Trial Managment
Successful completion of clinical trials requires that the investigator sites chosen are able to manage the trial process on time and within budget to ensure the high quality production of data.
eBiodata works with teams across the country to help select sites and investigators that are highly competent and deliver excellent levels of data for your trial.
We streamline site management, drawing on our national networks of experienced investigators and study sites to ensure rapid commitment, contracting, IRB approval, training and set-up.
eBiodata staff are committed to speed the learning curve, improve protocol adherence and data accuracy, and minimize time and costs of your local study.
eBiodata is a full-service CRO providing the following services;
-
Clinical trials management,
-
Medical writing,
-
Selection and recruitment of Medical Centers and Health funds,
-
Site monitoring,
-
In-sourcing and Out-sourcing of monitors
-
Regulatory services,
-
Data Management and Biostatistics services,
-
Business consultation,

Consulting Services
We still have only a very limited understanding of most aspects about our planet. Answering questions about this is essential for understanding the mechanistic role it plays on other scientific processes, and for developing tools to further explore this research avenue with more sensitive measurements and improved data collection.